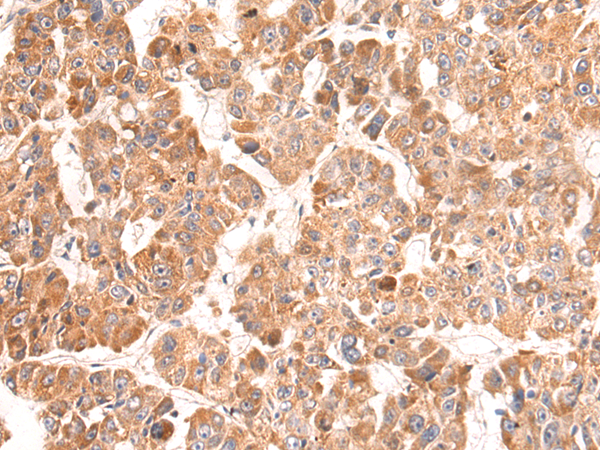

-
分类: 科研抗体货号: P10278别名: NS4ATP2应用: IHC反应种属: Human, Mouse
-
分类: 科研抗体货号: P10304别名: LCB应用: WB,IHC反应种属: Human, Mouse
-
分类: 科研抗体货号: P10293别名: PLC-beta-2应用: IHC反应种属: Human, Mouse, Rat
-
分类: 科研抗体货号: P10303别名: DS1; DS-1; ICT1; MRP-L58应用: IHC反应种属: Human, Mouse
-
分类: 科研抗体货号: P10308别名: IGO; 14.1; AGM2; IGL1; IGL5; IGLL; IGVPB; CD179b; VPREB2; IGLJ14.1应用: IHC反应种属: Human
-
分类: 科研抗体货号: P10292别名: NP22; NP24; NP25应用: IHC反应种属: Human, Mouse, Rat
-
分类: 科研抗体货号: P10302别名: URIM; L40mt; NLVCF; MRPL22; MRP-L22; MRP-L40应用: WB,IHC反应种属: Human
-
分类: 科研抗体货号: P10307别名: CYPC应用: WB,IHC反应种属: Human, Mouse
-
分类: 科研抗体货号: P10319别名: QR2; DHQV; DIA6; NMOR2应用: WB,IHC反应种属: Human, Mouse, Rat
-
分类: 科研抗体货号: P10301别名: WARBM3; RAB18LI1应用: IHC反应种属: Human, Mouse, Rat

鄂公网安备42018502007531号
鄂公网安备42018502007531号

